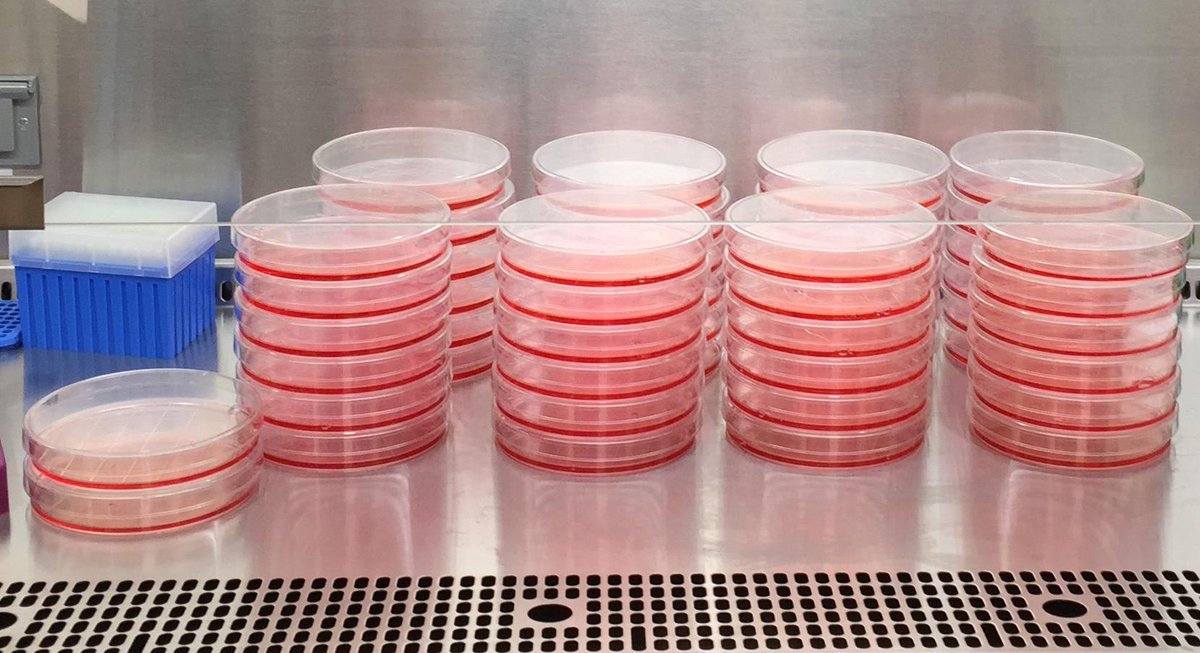
Vector Discovery starting a production run.  #GotPlates #AAV #4DMT

4DMT
@4dmolecular
Developing the best Adeno-Associated Vectors to meet unmet needs and unlock the true potential of gene therapy space. Check us out at 4DMT.com
ID: 3287993773
http://www.4dmt.com 22-07-2015 22:08:49
36 Tweet
191 Followers
55 Following













Thank you Razorfrog Web Design for the lovely chocolates. Check out more of their handiwork at 4dmt.com